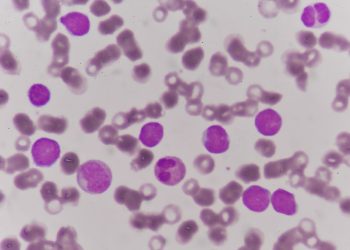
Acute Myeloid Leukemia

Types Of Cancer
What is Ewing Sarcoma?
Ewing sarcoma is a type of bone cancer. It's rare, and it usually happens in children and teenagers. It affects...
Read moreDetailsAcute Myeloid Leukemia
Acute myeloid leukemia (AML) is a cancer that starts in the blood and blood-forming tissues in your bone marrow. It...
Read moreDetailsUterine Cancer Treatment
Uterine cancer is the abnormal growth of tissue in the uterus, the organ in a woman’s pelvis that’s used for...
Read moreDetailsWhat is Kaposi Sarcoma?
Kaposi sarcoma is a type of tumour that develops on blood vessels and other soft tissue. It most commonly affects...
Read moreDetailsBasal Cell Cancer
Basal cell cancer starts in the skin’s basal cells, which are constantly growing and pushing older, dead skin off the...
Read moreDetailsBladder Cancer Symptoms
Bladder cancer is a type of cancer that starts in the tissues of the bladder. It can spread to other...
Read moreDetailsBladder Cancer – Symptoms and Treatment
Cancer starts in cells that grow and develop out of control, forming tumours or abnormalities that can damage other parts...
Read moreDetailsStomach Cancer – Symptoms and Treatment
Stomach cancer (also called gastric cancer) happens when stomach cells change and grow out of control, forming a tumour. It...
Read moreDetailsEndometrial Cancer Treatment
A tumor in the lining of the uterus (endometrium) is the most common type of cancer in women. The uterus...
Read moreDetailsOsteosarcoma
Osteosarcoma is a type of cancer that starts in bone cells. The cancer cells change the bones to grow faster...
Read moreDetails